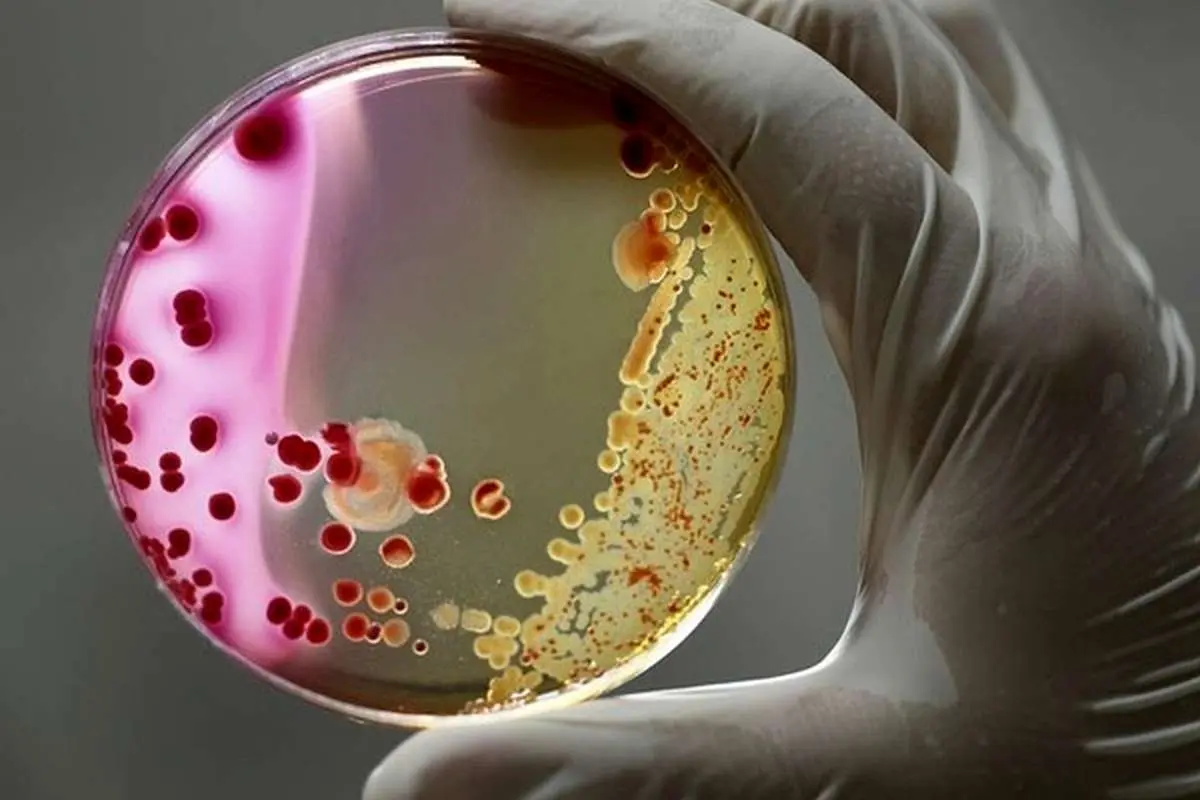

ناسا یک باکتری جهشیافته و خطرناک را در فضا کشف کرد
کشف جدید ناسا ممکن است شبیه به طرح یک فیلم جدید درباره بیگانگان به نظر برسد، اما این آژانس فضایی در واقعیت یک باکتری جهشیافته را در فضا پیدا کرده است.
ناسا از کشف ۱۳ سویه از یک باکتری جهشیافته در «ایستگاه فضایی بینالمللی» خبر داد که عامل عفونت خونی فضانوردان است.
به گزارش ایسنا، کشف جدید ناسا ممکن است شبیه به طرح یک فیلم جدید درباره بیگانگان به نظر برسد، اما این آژانس فضایی در واقعیت یک باکتری جهشیافته را در فضا پیدا کرده است.
پژوهشگران ناسا ۱۳ سویه را از باکتری «انتروباکتر بوگاندنسیس» (Enterobacter Bugandensis) کشف کردند که با بروز عفونتهای خونی در «ایستگاه فضایی بینالمللی» مرتبط هستند. این عفونتها میتوانند سلامتی فضانوردان را به خطر بیندازند.
محیط ناملایم ایستگاه فضایی بینالمللی مانند سطوح بالاتر دیاکسید کربن، به جهش باکتریها منجر میشود و وقتی باکتریها در معرض ریزگرانش قرار میگیرند، میتوانند در برابر آنتیبیوتیکها مقاومت کنند.
این باکتریها از فضانوردان استفاده کردند تا به آزمایشگاه مداری برسند و اکنون پژوهشگران هشدار دادهاند که ریزگرانش میتواند بر سلامتی فضانوردان تأثیر بگذارد و آنها را مستعد ابتلا به عفونت ناشی از باکتریها کند.
این جهش باعث شد که باکتریها در گروه پاتوژنهای «ESKAPE» قرار بگیرند. این گروه دربردارنده باکتریهایی است که عامل اصلی عفونت هستند و در برابر مراقبتهای پزشکی مقاومت میکنند.
این باکتریها با بروز عفونتهای شدید مانند عفونت خونی نوزادان موسوم به «سپسیس نوزادی» (Neonatal Sepsis) مرتبط هستند. عفونتهای ناشی از انتروباکتر میتوانند به بروز سپسیس، عفونتهای دستگاه ادراری، عفونتهای پوست و بافتهای نرم و همچنین «اندوکاردیت» (Endocarditis) منجر شوند که یک التهاب تهدیدکننده زندگی است.
پژوهشگران برای اولین بار در سال ۲۰۱۹ هنگام انجام دادن یک بررسی گسترده روی قارچها و باکتریهای ساکن در ایستگاه فضایی بینالمللی، ریزارگانیسمهایی را در بدن فضانوردان کشف کردند، اما اخیرا توانستند باکتریهای انتروباکتر بوگاندنسیس پیشرو را شناسایی کنند. آنها ۱۳ سویه از این باکتری را در سه قسمت از ایستگاه فضایی بینالمللی شناسایی کردند؛ چهار سویه در سیستم گردش هوا، یک سویه در دستگاه ورزشی و هشت سویه در حمام.
پژوهشگران در طول تحقیقات خود، به جای مقایسه کردن باکتریهای انتروباکتر بوگاندنسیس یافتشده در ایستگاه فضایی بینالمللی با تغییرات روی زمین، سه گام را برای شناسایی جهش باکتری برداشتند.
آنها ابتدا بررسی کردند که چگونه ژنوم باکتری و عملکرد آن در طول انطباق با محیط ناملایم فضا تغییر کرده است. این تعییرات پیش از رفتن به مرحله دوم رخ دادند. پژوهشگران در مرحله دوم، فراوانی جمعیت انتروباکتر بوگاندنسیس را در ایستگاه فضایی بینالمللی شناسایی کردند. در نهایت، پژوهشگران به بررسی تعاملات متابولیکی میان باکتریها پرداختند که به سایر ریزارگانیسمها در زنده ماندن و رشد کردن کمک میکنند.
ناسا گزارش داد: یافتههای این پژوهش نشان میدهند که در شرایط ناملایم، سویههای جداشده از ایستگاه فضایی بینالمللی جهش مییابند و از نظر ژنتیکی و عملکردی در مقایسه با همتایان زمینی خود متمایز میشوند. این سویهها طی بررسیها توانستند به مرور زمان به مقدار قابل توجهی در ایستگاه فضایی باقی بمانند. ژنومهای موجود در ایستگاه به طور میانگین ۴۵۶۸ ژن را نشان دادند که تعداد آنها به طور قابل توجهی بیشتر از میانگین ۴۴۱۶ ژن موجود در ژنومهای روی زمین است.
پژوهشگران به این نتیجه رسیدند که سویههای جهشیافته، ژنهای کاملا متفاوتی دارند و این ژنها ممکن است به ایجاد توانایی مقاومت در برابر چند دارو منجر شده باشند.
اگرچه یک گونه از انتروباکتر بوگاندنسیس روی زمین وجود دارد، اما شرایط ناملایم محیط ایستگاه فضایی بینالمللی مانند ریزگرانش، تابش خورشیدی و افزایش سطح دیاکسید کربن باعث میشوند که باکتریها برای زنده ماندن جهش یابند.
این پژوهش نشان میدهد که عوامل دیگری مانند تهویه، رطوبت و فشار هوا ممکن است به رشد باکتریهای انتروباکتر بوگاندنسیس کمک کرده باشند. همچنین، این پژوهش نشان میدهد که سویه باکتریایی میتواند با سایر ریزارگانیسمهای موجود در ایستگاه فضایی بینالمللی همزیستی داشته باشد و به بقای آنها کمک کند.
پژوهشگران با مطالعه چگونگی زنده ماندن ریزارگانیسمها در محیط ناملایم ایستگاه فضایی بینالمللی گفتند: این پژوهش، روزنههایی را به روی اقدامات پیشگیرانه مؤثر برای حفظ سلامتی فضانوردان باز میکند.













